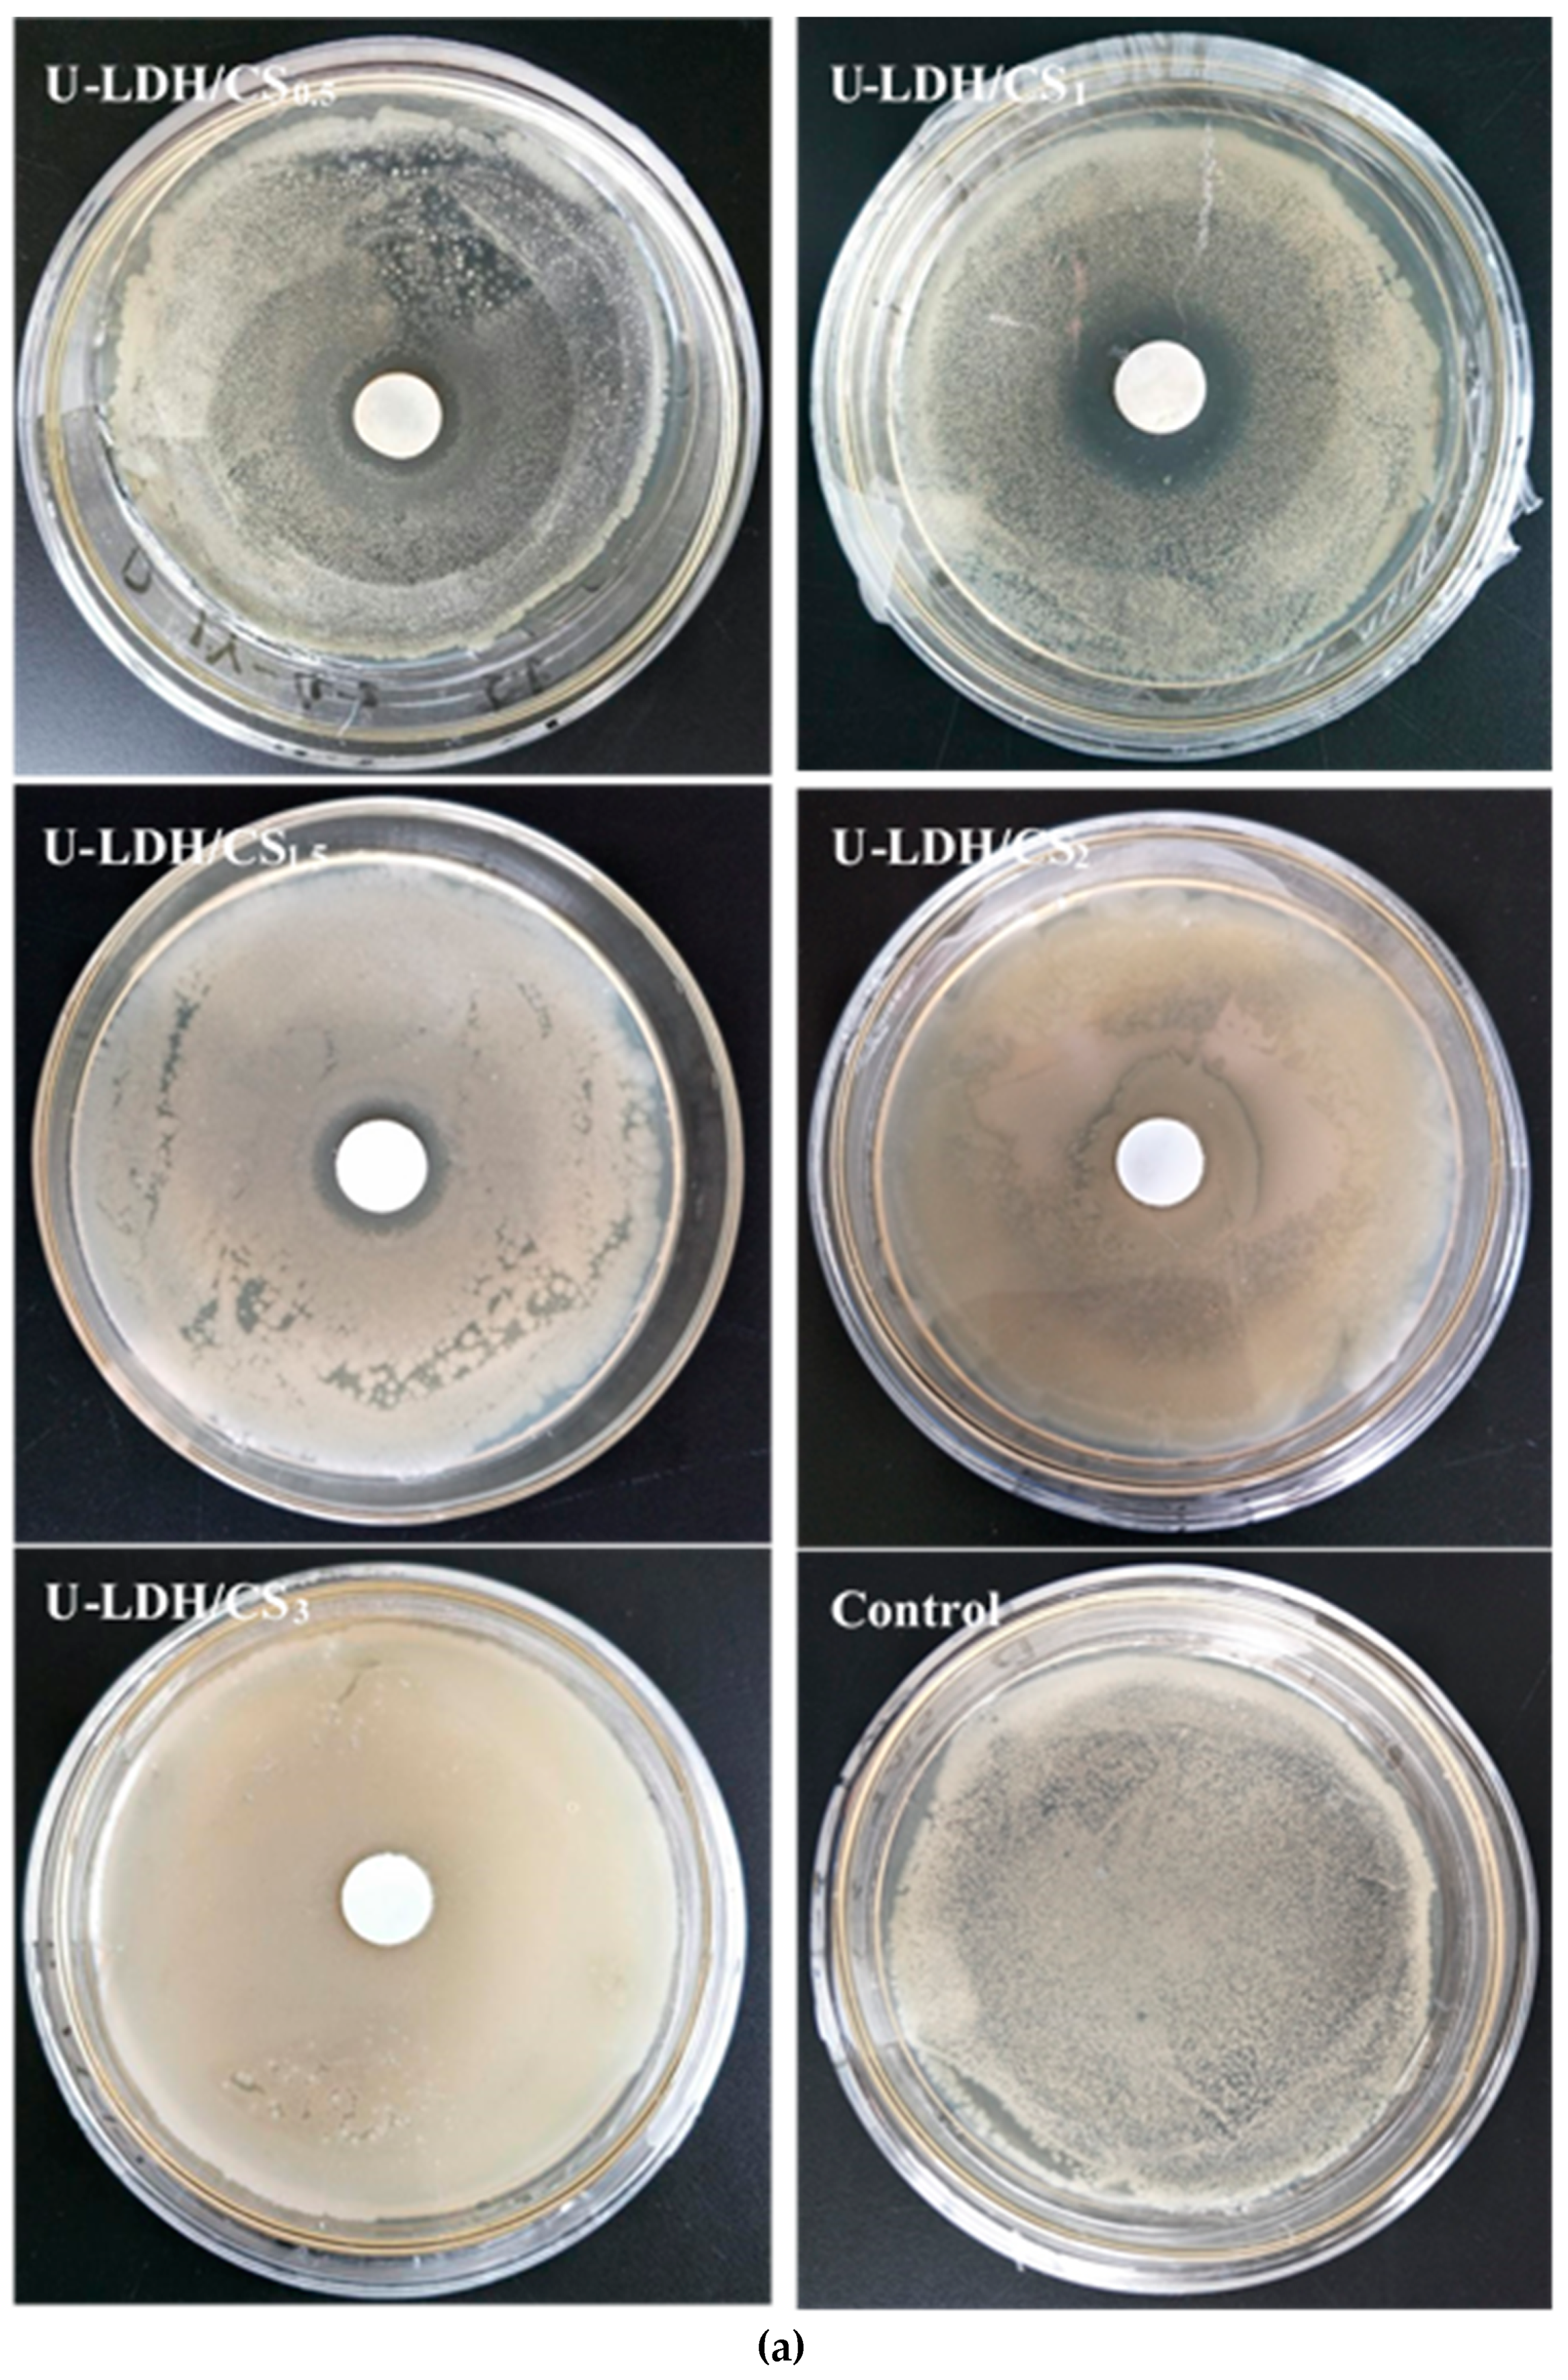
Polymers 11 01588 g009a Polymers 11 01588 g009a
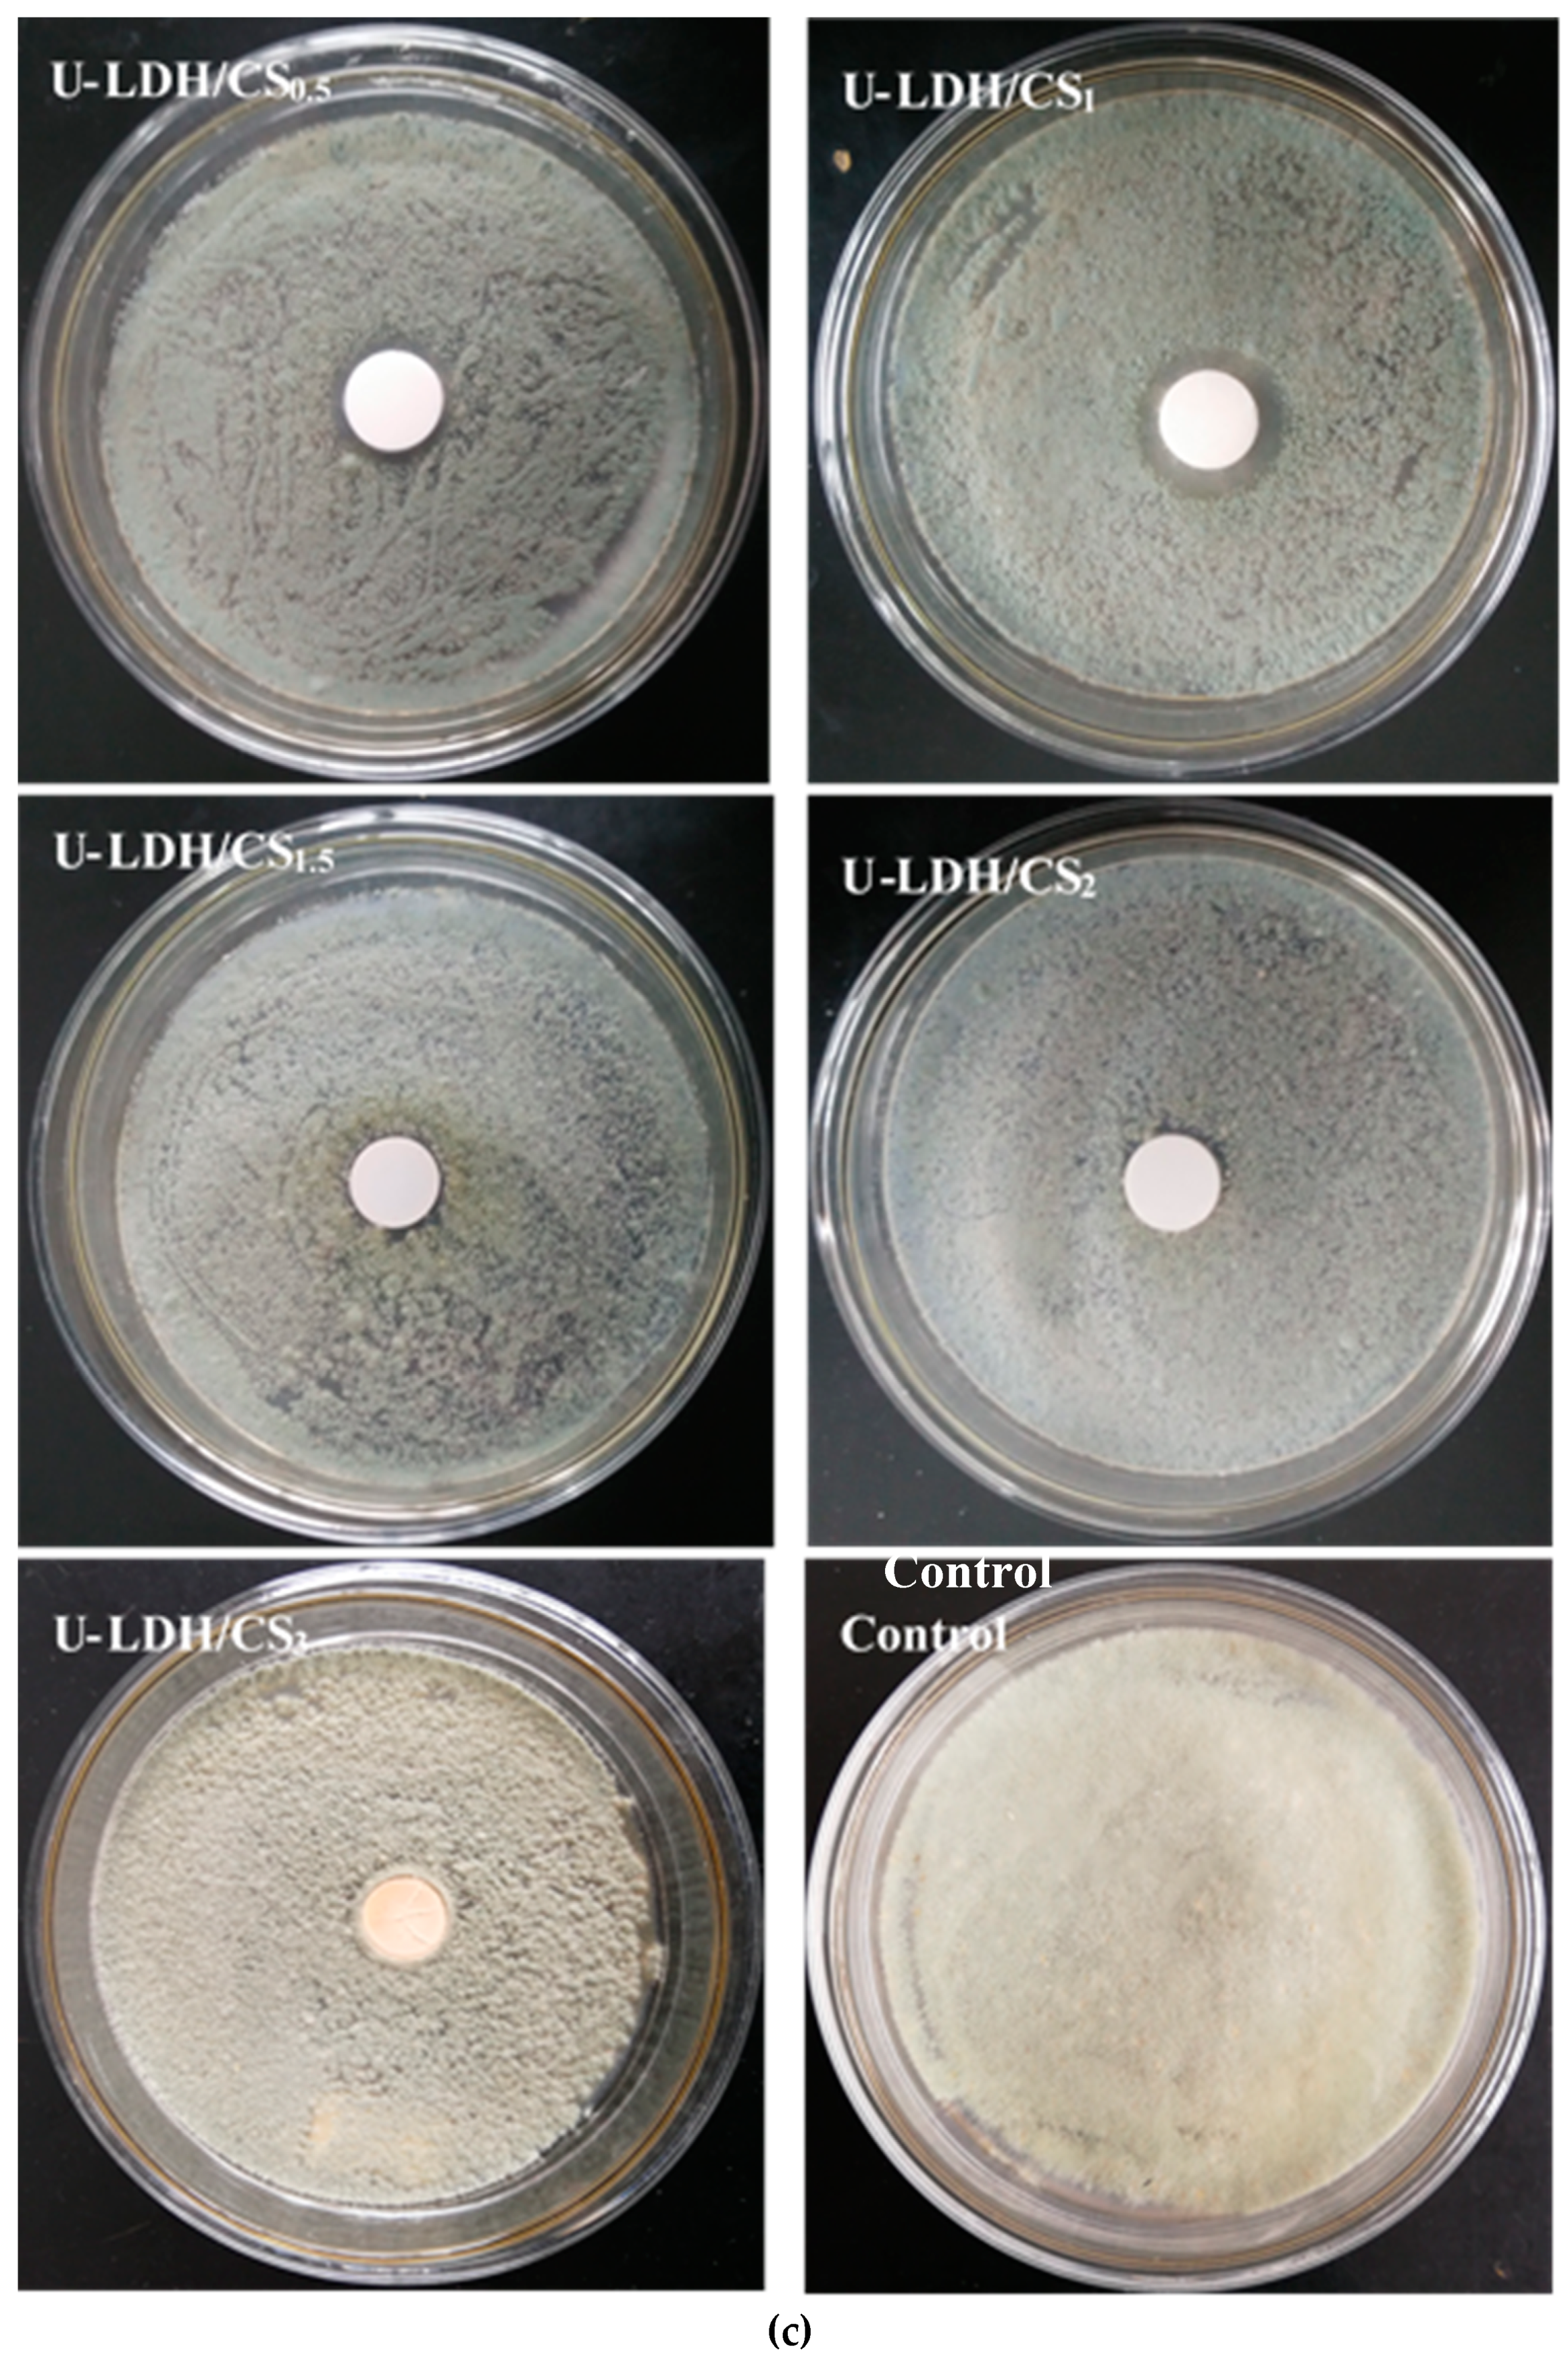
Polymers 11 01588 g009c Polymers 11 01588 g009c

Preparation of the Hybrids of Hydrotalcites and Chitosan by Urea Method and Their Antimicrobial Activities
Abstract
1. Introduction
2. Materials and Methods
2.1. Experimental Materials
2.2. Preparation of ZnAl Hydroxide and CS Hybrids
2.2.1. Preparation of the ZnAl Hydroxide by Urea Method
2.2.2. Preparation of the U-LDH5 and CS Hybrids
2.3. Characterization Techniques
2.3.1. XRD Analyses
2.3.2. FTIR Analyses
2.3.3. SEM Analyses
2.3.4. UV-Vis Analysis
2.3.5. Point Zero Charge Analysis
2.3.6. Rheological Analysis
2.3.7. Thermogravimetric Analysis
2.4. In Vitro Antimicrobial Assay
2.4.1. Microorganism and Media
2.4.2. Antimicrobial Test
3. Results and Discussion
3.1. Characterization of the U-LDH/CS Hybrids
3.1.1. XRD Analyses
3.1.2. FTIR Analyses
3.1.3. SEM Analysis
3.1.4. UV-Vis Analyses
3.1.5. Point Zero Charge Analysis
3.1.6. Rheological Analysis
3.1.7. Thermogravimetric Analysis
3.2. Antimicrobial Activity
4. Conclusions
Supplementary Materials
Author Contributions
Funding
Acknowledgments
Conflicts of Interest
References
- Nunes, D.; Pimentel, A.; Santos, L.; Barquinha, P.; Pereira, L.; Fortunato, E.; Martins, R. Textbook of Metal Oxide Nanostructures: Synthesis, Properties and Applications, 1st ed.; Elsevier: North-Holland, The Netherlands, 2018; p. 328. [Google Scholar]
- Follmann, H.D.; Messias, I.; Queiroz, M.N.; Araujo, R.A.; Rubira, A.F.; Silva, R. Designing hybrid materials with multifunctional interfaces for wound dressing, electrocatalysis, and chemical separation. J. Colloid Interface Sci. 2019, 533, 106–125. [Google Scholar] [CrossRef] [PubMed]
- Ananikov, V.P.; Eremin, D.B.; Yakukhnov, S.A.; Dilman, A.D.; Levin, V.V.; Egorov, M.P.; Karlov, S.S.; Kustov, L.M.; Tarasov, A.L.; Greish, A.A.; et al. Organic and hybrid systems: From science to practice. Mendeleev Commun. 2017, 27, 425–438. [Google Scholar] [CrossRef]
- Toshima, N. Recent progress of organic and hybrid thermoelectric materials. Synth. Met. 2017, 225, 3–21. [Google Scholar] [CrossRef]
- Sirinakorn, T.; Imwiset, K.; Bureekaew, S.; Ogawa, M. Inorganic modification of layered silicates toward functional inorganic-inorganic hybrids. Appl. Clay Sci. 2018, 153, 187–197. [Google Scholar] [CrossRef]
- Jo, Y.K.; Lee, J.M.; Son, S.; Hwang, S.J. 2D inorganic nanosheet-based hybrid photocatalysts: Design, applications, and perspectives. J. Photochem. Photobiol. C Photochem. Rev. 2018, 40, 150–190. [Google Scholar] [CrossRef]
- Zhu, J.; Wen, M.; Wen, W.; Du, D.; Zhang, X.; Wang, S.; Lin, Y. Recent progress in biosensors based on organic-inorganic hybrid nanoflowers. Biosens. Bioelectron. 2018, 120, 175–187. [Google Scholar] [CrossRef] [PubMed]
- Ma, Y.; Chen, L.; Ye, Y.; Wan, H.; Zhou, H.; Chen, J. Preparation and tribological behaviors of a novel organic-inorganic hybrid resin bonded solid lubricating coating cured by ultraviolet radiation. Prog. Org. Coat. 2019, 127, 348–358. [Google Scholar] [CrossRef]
- Sharaha, U.; Rodriguez-Diaz, E.; Riesenberg, K.; Bigio, I.J.; Huleihel, M.; Salman, A. Using Infrared Spectroscopy and Multivariate Analysis to Detect Antibiotics’ Resistant Escherichia coli Bacteria. Anal. Chem. 2017, 89, 8782–8790. [Google Scholar] [CrossRef]
- Gagnon, K.J.; Perry, H.P.; Clearfield, A. Chem Inform Abstract: Conventional and Unconventional Metal-Organic Frameworks Based on Phosphonate Ligands: MOFs and UMOFs. Chem. Rev. 2012, 43, 1034–1054. [Google Scholar] [CrossRef]
- Zhang, T.; Zhou, Y.; Wang, Y.; Zhang, L.; Wang, H.; Wu, X. Fabrication of hierarchical nanostructured BSA/ZnO hybrid nanoflowers by a self-assembly process. Mater. Lett. 2014, 128, 227–230. [Google Scholar] [CrossRef]
- Wang, X.; Lou, T.; Zhao, W.; Song, G. Preparation of pure chitosan film using ternary solvents and its super absorbency. Carbohydr. Polym. 2016, 153, 253–257. [Google Scholar] [CrossRef] [PubMed]
- Ge, H.C.; Hua, T.T. Synthesis and characterization of poly (maleic acid)-grafted crosslinked chitosan nanomaterial with high uptake and selectivity for Hg (II) sorption. Carbohyd. Polym. 2016, 153, 246–252. [Google Scholar] [CrossRef] [PubMed]
- Zubair, M.; Daud, M.; McKay, G.; Shehzad, F.; Al-Harthi, M.A. Recent progress in layered double hydroxides (LDH)-containing hybrids as adsorbents for water remediation. Appl. Clay Sci. 2017, 143, 279–292. [Google Scholar] [CrossRef]
- Khan, S.; Kamal, T.; Asiri, A.; Akhtar, K.; Khan, S. Recent Development of Chitosan Nanocomposites for Environmental Applications. Recent Pat. Nanotechnol. 2016, 10, 181–188. [Google Scholar] [CrossRef] [PubMed]
- Choi, C.; Nam, J.-P.; Nah, J.-W. Application of chitosan and chitosan derivatives as biomaterials. J. Ind. Eng. Chem. 2016, 33, 1–10. [Google Scholar] [CrossRef]
- Thomas, V.; Yallapu, M.M.; Sreedhar, B.; Bajpai, S.K. Fabrication, Characterization of Chitosan/Nanosilver Film and Its Potential Antibacterial Application. J. Biomater. Sci. Polym. Ed. 2009, 20, 2129–2144. [Google Scholar] [CrossRef]
- Ruiz-Hitzky, E.; Aranda, P.; Darder, M.; Rytwo, G. Hybrid materials based on clays for environmental and biomedical applications. J. Mater. Chem. 2010, 20, 9306. [Google Scholar] [CrossRef]
- Cunha, V.R.R.; Guilherme, V.A.; De Paula, E.; De Araujo, D.R.; Silva, R.O.; Medeiros, J.V.R.; Leite, J.R.S.A.; Peterson, P.A.D.; Foldvari, M.; Petrilli, H.M.; et al. Delivery system for mefenamic acid based on the nanocarrier layered double hydroxide: Physicochemical characterization and evaluation of anti-inflammatory and antinociceptive potential. Mater. Sci. Eng. C 2016, 58, 629–638. [Google Scholar] [CrossRef]
- Ferraris, S.; Spriano, S. Review Antibacterial titanium surfaces for medical implants. Adv. Mater. Sci. Eng.C 2016, 61, 965–978. [Google Scholar] [CrossRef]
- Mishra, G.; Dash, B.; Pandey, S.; Mohanty, P.P. Antibacterial actions of silver nanoparticles incorporated Zn-Al layered double hydroxide and its spinel. J. Environ. Chem. Eng. 2013, 1, 1124–1130. [Google Scholar] [CrossRef]
- Li, B.; Zhang, Y.; Yang, Y.; Qiu, W.; Wang, X.; Liu, B.; Wang, Y.; Sun, G. Synthesis, characterization, and antibacterial activity of chitosan/TiO2 nanocomposite against Xanthomonas oryzae pv. oryzae. Carbohydr. Polym. 2016, 152, 825–831. [Google Scholar] [CrossRef] [PubMed]
- Sahariah, P.; Másson, M. Antimicrobial Chitosan and Chitosan Derivatives: A Review of the Structure–Activity Relationship. Biomacromolecules 2017, 18, 3846–3868. [Google Scholar] [CrossRef] [PubMed]
- Liu, H.; Du, Y.; Wang, X.; Sun, L. Chitosan kills bacteria through cell membrane damage. Int. J. Food Microbiol. 2004, 95, 147–155. [Google Scholar] [CrossRef] [PubMed]
- Helander, I.; Nurmiaho-Lassila, E.-L.; Ahvenainen, R.; Rhoades, J.; Roller, S. Chitosan disrupts the barrier properties of the outer membrane of Gram-negative bacteria. Int. J. Food Microbiol. 2001, 71, 235–244. [Google Scholar] [CrossRef]
- Zheng, L.Y.; Zhu, J.F. Study of antimicrobial activity of chitosan with different molecular weight. Carbohyd. Polym. 2003, 54, 527–530. [Google Scholar] [CrossRef]
- Zeng, H.-Y.; Deng, X.; Wang, Y.-J.; Liao, K.-B. Preparation of Mg-Al hydrotalcite by urea method and its catalytic activity for transesterification. AIChE J. 2009, 55, 1229–1235. [Google Scholar] [CrossRef]
- Li, S.-P.; Hou, W.-G.; Han, S.-H.; Li, L.-F.; Zhao, W.-A. Studies on intrinsic ionization constants of Fe–Al–Mg hydrotalcite-like compounds. J. Colloid Interface Sci. 2003, 257, 244–249. [Google Scholar] [CrossRef]
- Barka, E.A.; Gognies, S.; Nowak, J.; Audran, J.-C.; Belarbi, A. Inhibitory effect of endophyte bacteria on Botrytis cinerea and its influence to promote the grapevine growth. Biol. Control 2002, 24, 135–142. [Google Scholar] [CrossRef]
- Yi, J.-Z.; Zhang, L.-M. Studies of sodium humate/polyacrylamide/clay hybrid hydrogels. I. Swelling and rheological properties of hydrogels. Eur. Polym. J. 2007, 43, 3215–3221. [Google Scholar] [CrossRef]
- Zheng, Z.; Levin, R.E.; Pinkham, J.L.; Shetty, K. Decolorization of polymeric dyes by a novel Penicillium isolate. Process Biochem. 1999, 34, 31–37. [Google Scholar] [CrossRef]
- Hou, W.-G.; Su, Y.-L.; Sun, D.-J.; Zhang, C.-G. Studies on Zero Point of Charge and Permanent Charge Density of Mg-Fe Hydrotalcite-like Compounds. Langmuir 2001, 17, 1885–1888. [Google Scholar] [CrossRef]
- Jahangirian, H.; Haron, M.J.; Shah, M.H.; Abdollahi, Y.A.; Rezayi, M.A.; Vafaei, N.A. Well diffusion method for evaluation of antibacterial activity of copper phenyl fatty hydroxamate synthesized from canola and palm kernel oils. Dig. J. Nanomater. Biostruct. 2013, 8, 1263–1270. [Google Scholar]
- Luo, L.; Li, Q.; Xu, Y.; Ding, Y.; Wang, X.; Deng, D.; Xu, Y. Amperometric glucose biosensor based on NiFe2O4 nanoparticles and chitosan. Sens. Actuators B Chem. 2010, 145, 293–298. [Google Scholar] [CrossRef]
- Viswanathan, N.; Meenakshi, S. Enriched fluoride sorption using alumina/chitosan composite. J. Hazard. Mater. 2010, 178, 226–232. [Google Scholar] [CrossRef] [PubMed]
- Si, Y.; Samulski, E.T. Synthesis of water soluble grapheme. Nano Lett. 2008, 8, 1679–1682. [Google Scholar] [CrossRef] [PubMed]
- Pawlak, A.; Mucha, M. Thermogravimetric and FTIR studies of chitosan blends. Thermochim. Acta 2003, 396, 153–166. [Google Scholar] [CrossRef]
- Darder, M.; Colilla, M.; Ruiz-Hitzky, E. Chitosan-clay nanocomposites: Application as electrochemical sensors. Appl. Clay Sci. 2005, 28, 199–208. [Google Scholar] [CrossRef]
- Darder, M.; Colilla, M.; Ruiz-Hitzky, E. Biopolymer-Clay Nanocomposites Based on Chitosan Intercalated in Montmorillonite. Chem. Mater. 2003, 15, 3774–3780. [Google Scholar] [CrossRef]
- Krishnamoorti, R.; Giannelis, E.P. Rheology of End-Tethered Polymer Layered Silicate Nanocomposites. Macromology 1997, 30, 4097–4102. [Google Scholar] [CrossRef]
- Costa, F.R.; Wagenknecht, U.; Jehnichen, D.; Goad, M.A.; Heinrich, G. Nanocomposites based on polyethylene and Mg-Al layered double hydroxide. Part II. Rheological characterization. Polymer 2006, 47, 1649–1660. [Google Scholar] [CrossRef]
- Cárdenas, G.; Miranda, S.P. FTIR and TGA studies of chitosan composite films. J. Chil. Chem. Soc. 2004, 49, 291–295. [Google Scholar] [CrossRef]
- Kumar, S.; Koh, J. Physiochemical, Optical and Biological Activity of Chitosan-Chromone Derivative for Biomedical Applications. Int. J. Mol. Sci. 2012, 13, 6102–6116. [Google Scholar] [CrossRef] [PubMed]
- Taboada, E. Retención de Metales Pesados Utilizando Quitosano y Derivados. Ph.D. Thesis, Universidad de Concepción, Concepción, Chile, January 2003. [Google Scholar]
- Vágvölgyi, V.; Palmer, S.J.; Kristóf, J.; Frost, R.L.; Horváth, E. Mechanism for hydrotalcite decomposition: A controlled rate thermal analysis study. J. Colloid Interface Sci. 2008, 318, 302–308. [Google Scholar] [CrossRef] [PubMed]
- Tichit, D.; Rolland, A.; Prinetto, F.; Fetter, G.; Martinez-Ortiz, M.D.J.; Valenzuela, M.A.; Bosch, P. Comparison of the structural and acid???base properties of Ga- and Al-containing layered double hydroxides obtained by microwave irradiation and conventional ageing of synthesis gels. J. Mater. Chem. 2002, 12, 3832–3838. [Google Scholar] [CrossRef]
- Ahmed, A.A.A.; Talib, Z.A.; Bin Hussein, M.Z. Thermal, optical and dielectric properties of Zn–Al layered double hydroxide. Appl. Clay Sci. 2012, 56, 68–76. [Google Scholar] [CrossRef]
- Auwalu, A.; Linlin, T.; Ahmad, S.; Hongying, Y.; Zhenan, J.; Song, Y. Preparation and application of metal ion-doped CoMgAl-hydrotalcite visible-light-driven photocatalyst. Int. J. Ind. Chem. 2019, 10, 121–131. [Google Scholar] [CrossRef]
- Elhalil, A.; Elmoubarki, R.; Machrouhi, A.; Sadiq, M.; Abdennouri, M.; Qourzal, S.; Barka, N. Photocatalytic degradation of caffeine by ZnO-ZnAl2O4 nanoparticles derived from LDH structure. J. Environ. Chem. Eng. 2017, 5, 3719–3726. [Google Scholar] [CrossRef]
- Kong, M.; Chen, X.G.; Xing, K.; Park, H.J. Antimicrobial properties of chitosan and mode of action: A state of the art review. Int. J. Food Microbiol. 2010, 144, 51–63. [Google Scholar] [CrossRef]
- Simunek, J.; Brandysova, V.; Koppova, I.; Simunek, J., Jr. The antimicrobial action of chitosan, low molar mass chitosan, and chitooligosaccharides on human colonic bacteria. Folia Microbiol. 2012, 57, 341–345. [Google Scholar] [CrossRef]
- Jung, E.J.; Youn, D.K.; Lee, S.H.; No, H.K.; Ha, J.G.; Prinyawiwatkul, W. Antibacterial activity of chitosans with different degrees of deacetylation and viscosities. Int. J. Food Sci. Technol. 2010, 45, 676–682. [Google Scholar] [CrossRef]
- Aiedeh, K.; Taha, M.O. Synthesis of iron-crosslinked chitosan succinate and iron-crosslinked hydroxamated chitosan succinate and their in vitro evaluation as potential matrix materials for oral theophylline sustained-release beads. Eur. J. Pharm. Sci. 2001, 13, 159–168. [Google Scholar] [CrossRef]
- Sudarshan, N.R.; Hoover, D.G.; Knorr, D. Antibacterial action of chitosan. Food Biotechnol. 1992, 6, 257–272. [Google Scholar] [CrossRef]
- Kong, M.; Chen, X.G.; Liu, C.S.; Yu, L.J.; Ji, Q.X.; Xue, Y.P.; Cha, D.S.; Park, H.J. Preparation and antibacterial activity of chitosan microspheres in a solid dispersing system. Front. Mater. Sci. 2008, 2, 214–220. [Google Scholar] [CrossRef]
- Andres, Y.; Giraud, L.; Gerente, C.; Le Cloirec, P. Antibacterial Effects of Chitosan Powder: Mechanisms of Action. Environ. Technol. 2007, 28, 1357–1363. [Google Scholar] [CrossRef] [PubMed]
- Sahariah, P.; Óskarsson, B.M.; Hjálmarsdóttir, M.A.; Másson, M. Synthesis of guanidinylated chitosan with the aid of multiple protecting groups and investigation of antibacterial activity. Carbohydr. Polym. 2015, 127, 407–417. [Google Scholar] [CrossRef]
- Dutta, P.; Tripathi, S.; Mehrotra, G.; Dutta, J. Perspectives for chitosan based antimicrobial films in food applications. Food Chem. 2009, 114, 1173–1182. [Google Scholar] [CrossRef]
- Papineau, A.M.; Hoover, D.G.; Knorr, D.; Farkas, D.F. Antimicrobial effect of water-soluble chitosans with high hydrostatic pressure. Food Biotechnol. 1991, 5, 45–57. [Google Scholar] [CrossRef]
- Bai, R.-K.; Huang, M.-Y.; Jiang, Y.-Y. Selective permeabilities of chitosan-acetic acid complex membrane and chitosan-polymer complex membranes for oxygen and carbon dioxide. Polym. Bull. 1988, 20, 83–88. [Google Scholar] [CrossRef]
- Hosseinnejad, M.; Jafaria, S.M. Evaluation of different factors affecting antimicrobial properties of chitosan. Int. J. Biol. Macromol. 2016, 85, 467–475. [Google Scholar] [CrossRef] [PubMed]
- Severino, R.; Vu, K.D.; Donsi’, F.; Salmieri, S.; Ferrari, G.; Lacroix, M. Antimicrobial effects of different combined non-thermal treatments against Listeria monocytogenes in broccoli florets. J. Food Eng. 2014, 124, 1–10. [Google Scholar] [CrossRef]
- Chien, R.-C.; Yen, M.-T.; Mau, J.-L. Antimicrobial and antitumor activities of chitosan from shiitake stipes, compared to commercial chitosan from crab shells. Carbohydr. Polym. 2016, 138, 259–264. [Google Scholar] [CrossRef] [PubMed]
- Li, Z.; Yang, F.; Yang, R. Synthesis and characterization of chitosan derivatives with dual-antibacterial functional groups. Int. J. Biol. Macromol. 2015, 75, 378–387. [Google Scholar] [CrossRef] [PubMed]
- Yuan, G.; Lv, H.; Tang, W.; Zhang, X.; Sun, H. Effect of chitosan coating combined with pomegranate peel extract on the quality of Pacific white shrimp during iced storage. Food Control 2016, 59, 818–823. [Google Scholar] [CrossRef]
- Zhang, H.; Lv, X.-J.; Li, Y.; Wang, Y.; Li, J. P25-Graphene Composite as a High Performance Photocatalyst. ACS Nano 2009, 4, 380–386. [Google Scholar] [CrossRef] [PubMed]
- Prasad, R.; Basavaraju, D.; Rao, K.; Naveen, C.; Endrino, J.; Phani, A. Nanostructured TiO2 and TiO2-Ag antimicrobial thin fifilms. In Proceedings of the 2011 International Conference on Nanoscience, Technology and Societal Implications (NSTSI), Bhubaneswar, India, 8–10 December 2011. [Google Scholar]
- Premanathan, M.; Karthikeyan, K.; Jeyasubramanian, K.; Manivannan, G. Selective toxicity of ZnO nanoparticles toward Gram-positive bacteria and cancer cells by apoptosis through lipid peroxidation. Nanomed. Nanotechnol. Biol. Med. 2011, 7, 184–192. [Google Scholar]
- Li, M.; Zhu, L.; Lin, D. Toxicity of ZnO nanoparticles to Escherichia coli: Mechanism and the inflfluence of medium components. Environ. Sci. Technol. 2011, 45, 1977–1983. [Google Scholar] [CrossRef] [PubMed]
- Wong, S.W.; Leung, P.T.; Djurišić, A.B.; Leung, K.M. Toxicities of nano zinc oxide to five marine organisms: Influences of aggregate size and ion solubility. Anal. Bioanal. Chem. 2010, 396, 609–618. [Google Scholar] [CrossRef] [PubMed]
- Wu, B.; Wang, Y.; Lee, Y.-H.; Horst, A.; Wang, Z.; Chen, D.-R.; Sureshkumar, R.; Tang, Y.J. Comparative Eco-Toxicities of Nano-ZnO Particles under Aquatic and Aerosol Exposure Modes. Environ. Sci. Technol. 2010, 44, 1484–1489. [Google Scholar] [CrossRef] [PubMed]

| Samples Reflections | U-LDH5 | U-LDH/CS0.5 | U-LDH/CS1 | U-LDH/CS1.5 | U-LDH/CS2 | U-LDH/CS3 |
|---|---|---|---|---|---|---|
| d003 (nm) | 0.7691 | 0.7627 | 0.7680 | 0.7596 | 0.7659 | 0.7568 |
| d006 (nm) | 0.3828 | 0.3803 | 0.3818 | 0.3795 | 0.3813 | 0.3785 |
| d009 (nm) | 0.2487 | 0.2595 | 0.2597 | 0.2594 | 0.2598 | 0.2586 |
| d110 (nm) | 0.1631 | 0.1635 | 0.1630 | 0.1635 | 0.1636 | 0.1630 |
| FW003 (rad) | 0.4080 | 0.2240 | 0.2560 | 0.2990 | 0.260 | 0.5100 |
| FW110 (rad) | 0.7770 | 0.4760 | 0.1810 | 0.6500 | 0.79 | 0.6700 |
| a (nm) | 0.3262 | 0.3204 | 0.3895 | 0.2493 | 0.1640 | 0.9613 |
| c (nm) | 2.3073 | 2.2471 | 2.2743 | 2.2802 | 2.2097 | 2.2174 |
| Samples g | E. coli | S. aureus | P. cyclopium |
|---|---|---|---|
| Control | 0 mm | 0 mm | 0 mm |
| Pure CS | 0 mm | 0 mm | 0 mm |
| U-LDH5 | 16.5 ± 0.3 mm | 20.5 ± 0.6 mm | 9.8 ± 0.7 mm |
| U-LDH/CS0.5 | 18.3 ± 0.4 mm | 23.2 ± 0.2 mm | 13.3 ± 0.7 mm |
| U-LDH/CS1 | 24.2 ± 0.8 mm | 30.4 ± 0.5 mm | 22.3 ± 0.5 mm |
| U-LDH/CS1.5 | 17.1 ± 0.3 mm | 27.0 ± 0.6 mm | 0mm |
| U-LDH/CS2 | 0 mm | 14mm | 0 mm |
| U-LDH/CS3 | 0 mm | 0 mm | 0 mm |
| Tetracycline* | 21 ± 0.9mm | 26 ± 0.9 mm | 21 ± 0.8 mm |
© 2019 by the authors. Licensee MDPI, Basel, Switzerland. This article is an open access article distributed under the terms and conditions of the Creative Commons Attribution (CC BY) license (http://creativecommons.org/licenses/by/4.0/).
Share and Cite
Gohi, B.F.C.A.; Zeng, H.-Y.; Cao, X.-J.; Zou, K.-M.; Shuai, W.; Diao, Y. Preparation of the Hybrids of Hydrotalcites and Chitosan by Urea Method and Their Antimicrobial Activities. Polymers 2019, 11, 1588. https://doi.org/10.3390/polym11101588
Gohi BFCA, Zeng H-Y, Cao X-J, Zou K-M, Shuai W, Diao Y. Preparation of the Hybrids of Hydrotalcites and Chitosan by Urea Method and Their Antimicrobial Activities. Polymers. 2019; 11(10):1588. https://doi.org/10.3390/polym11101588
Chicago/Turabian StyleGohi, Bi Foua Claude Alain, Hong-Yan Zeng, Xiao-Ju Cao, Kai-Min Zou, Wenlin Shuai, and Yi Diao. 2019. "Preparation of the Hybrids of Hydrotalcites and Chitosan by Urea Method and Their Antimicrobial Activities" Polymers 11, no. 10: 1588. https://doi.org/10.3390/polym11101588
APA StyleGohi, B. F. C. A., Zeng, H.-Y., Cao, X.-J., Zou, K.-M., Shuai, W., & Diao, Y. (2019). Preparation of the Hybrids of Hydrotalcites and Chitosan by Urea Method and Their Antimicrobial Activities. Polymers, 11(10), 1588. https://doi.org/10.3390/polym11101588

